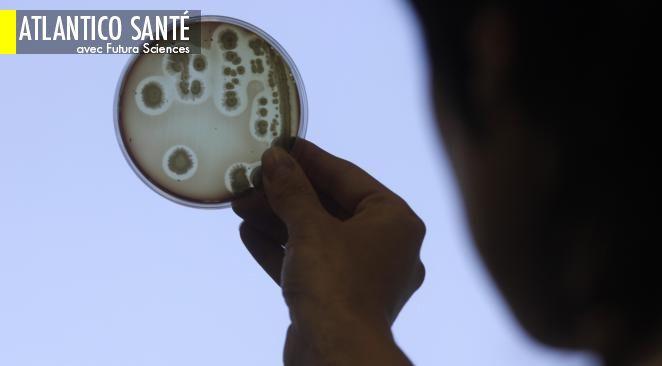
Article cover

Une étude publiée dans la revue Neurology montre qu'il n'y a apparemment aucun lien entre la vaccination contre l'Hépatite B et l'apparition de la sclérose en plaques.
15 août 2019Contenus en rapport avec le mot-clé sclérose en plaques
Sclérose en plaquesPourquoi cette étude confirme l'absence de lien entre vaccination et sclérose en plaques (mais ne suffira probablement pas à recréer la confiance)
Inégalité sur le plan de la santéLa sclérose en plaques touche de plus en plus les femmes
La sclérose en plaques touche une proportion de plus en plus importante de femmes ces dernières décennies. Cette évolution s’explique notamment suite aux modifications du mode de vie.
30 mai 2018Journée mondiale de la sclérose en plaquesSclérose en plaques : entre méconnaissance des causes et traitements peu efficaces, ces enjeux qui entourent cette maladie
La journée mondiale de la sclérose en plaques (SEP) a lieu ce 30 mai et permet d'attirer l'attention sur une maladie mal connue du grand public.
30 mai 2018NonLa justice refuse de remettre en liberté Tariq Ramadan
Les juges trouvent que le risque de récidive est trop important pour que le théologien musulman soit remis en liberté.
27 février 201804
Atlantico SantéCésarienne : plus de risque d'obésité et d'asthme pour l'enfant ; Sclérose en plaques : les hommes moins à risque grâce à la testostérone
Et aussi : Les bienfaits du pamplemousse ; Sommeil : les enfants dorment un peu moins les nuits de pleine lune ; Peut-on boire de la neige ?
1 février 2018Bonnes feuilles"Un beau jour, on m’a diagnostiqué une SEP. Une quoi ? Une sclérose en plaques. Mais cela reste un détail, car on m’a surtout diagnostiqué une Super Envie de Partir"
Etudiante en école de commerce, l'auteure apprend à 21 ans qu'elle est atteinte de sclérose en plaques (SEP). Après le choc du diagnostic et le choix du traitement, elle décide de faire un grand voyage afin de se réapproprier son corps et son esprit, dont l'équilibre est mis à mal par la maladie. Elle raconte sa découverte de la Nouvelle-Zélande, de la Birmanie et de la Mongolie (Extrait de Seper Hero, "Comment la maladie a donné du sens à ma vie" de Marine Barnerias publié chez Flammarion 2/2)
26 mai 2017Bonnes feuillesLa sclérose en plaques, cette maladie qui arrive sans prévenir
Etudiante en école de commerce, l'auteure apprend à 21 ans qu'elle est atteinte de sclérose en plaques (SEP). Après le choc du diagnostic et le choix du traitement, elle décide de faire un grand voyage afin de se réapproprier son corps et son esprit, dont l'équilibre est mis à mal par la maladie. Elle raconte sa découverte de la Nouvelle-Zélande, de la Birmanie et de la Mongolie (Extrait de Seper Hero, "Comment la maladie a donné du sens à ma vie" de Marine Barnerias publié chez Flammarion 1/2)
25 mai 2017Atlantico SantéL’OMS liste 12 "superbactéries" contre lesquelles il est urgent d’agir ; L’espérance de vie va continuer à progresser dans les pays développés
Et aussi : Sclérose en plaques : une nouvelle piste pour régénérer de la myéline ; Libido : le sport intense réduirait le désir masculin ; Méditation de pleine conscience : des souris servent de modèle animal.
2 mars 2017Atlantico SantéLes bienfaits de la méditation validés par la science ; le vélo, mieux que la marche pour mincir
Et aussi : Découverte d'un anticorps efficace contre la sclérose en plaques ; dopage : comment savoir si un produit est dopant ? ; des bactériophages pour contrer les bactéries résistantes aux antibiotiques
28 juillet 2016Atlantico SantéContre le diabète, une nouvelle protéine serait une bonne arme ; les mères de familles nombreuses vieilliraient moins vite
Et aussi : Dossier : les méningites, leurs dangers et leurs traitements ; science décalée : les bisous des mamans guérissent-ils les bobos ? ; en bref : de la vitamine D pour lutter contre la sclérose en plaques
14 janvier 2016Atlantico santéScience décalée : l'amour rend vraiment ivre ; à forte dose, le sel pourrait retarder la puberté
Et aussi : Le Lei gong teng, une plante chinoise pour traiter l’obésité ? ; Sclérose en plaques : certains aliments freineraient la maladie ; Pour avoir un ventre plat, mieux vaut ne pas sauter de repas.
28 mai 2015Douloureuse expérienceQuand la lenteur des procédures judiciaires aggrave la santé des malades
En France, une procédure judiciaire simple peut durer très longtemps. Une situation difficile qui devient insupportable lorsqu'on est très malade. Un patient du docteur Michel Dib en a d'ailleurs fait la douloureuse expérience.
15 mai 2015On tient une piste Sida : les traitements anti-VIH protégeraient-ils de la sclérose en plaque ?
Selon une étude australo-britannique, les porteurs du virus du sida (VIH) auraient 62% moins de risques d'être atteints de scléroses en plaque que le reste de la population.
18 août 2014Ça vient de sortirLe Sativex, un médicament dérivé du cannabis autorisé en France
Le ministère de la Santé l'a annoncé ce jeudi matin. C'est une première en France.
9 janvier 201414
Atlantico santéBaclofène : les ventes en hausse, les effets secondaires aussi ; la migraine abîmerait le cerveau
Et aussi : Les chimpanzés également touchés par la mort subite du sportif ; Le mystère du décalage horaire – un peu – élucidé ; La peste bubonique tue un jeune Kirghize de 15 ans.
5 septembre 2013Bonnes feuillesDe la sclérose en plaques au syndrome de Guillain-Barré : comment démasquer les hypocondriaques
A travers son témoignage personnel, l'auteur met le doigt sur un mal qui nous touche tous à divers degrés : l'hypocondrie. Extrait de "Confessions d'un hypocondriaque" (1/2).
3 août 2013